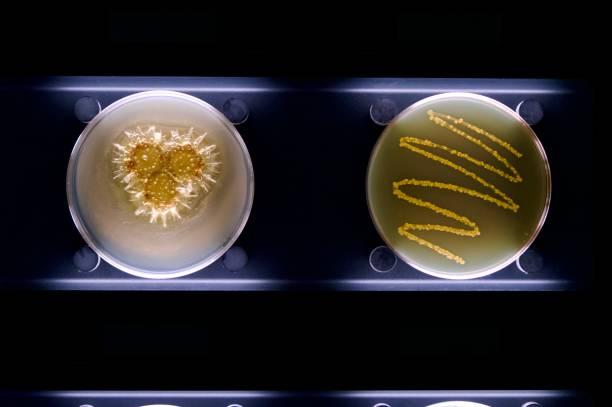

电话:19919999145
微信:17027022222
邮箱:kf@daiyun.cn
地址:国内、马来西亚、吉尔吉斯斯坦
发布时间:2024-01-16 点此:421次
三代试管胚胎缺陷强行移植有什么问题?
三代试管胚胎缺陷强行移植会出现很多问题,尤其是对女性的身体造成影响、胚胎移植后先兆流产、胚胎停育等等,所以为了避免这些危险,一般都会放弃。正常情况下,三代试管胚胎缺陷是无法移植的,大多数三代试管都是移植囊胚,经过胚胎筛查的,如果出现异常说明胚胎有问题,是要被舍弃的。另外,胚胎移植失败后胚胎一般会被身体吸收或是排出体外,当然移植失败后一定要去医院复查,密切观察胚胎组织是否完全排出体外。

三代试管婴儿移植所用的胚胎基本上都是囊胚,如果囊胚出现了缺陷是无法移植的,只能舍弃。此外,三代试管在胚胎植入前会进行基因的筛查和检测,进而了解胚胎的染色体是否正常,筛选出健康的胚胎进行移植,能够进一步提高实现优生优育。如果筛查出异常,那么说明胚胎有问题,这个时候就无法移植。
囊胚检测异常通常就是存在染色体异常的情况,一般是建议女性放弃进行移植的,因为移植之后成功率也是非常低的,不仅会对女性的身体造成影响还会增加试管的费用不值当;三代试管囊胚检测异常移植之后是非常容易出现先兆流产、胚胎停育等情况的,对于女性的身体危害是非常大的,因此不建议进行移植;即使存在异常的囊胚移植之后成功着床并怀孕了,但是胚胎的健康会受到一定的影响,可能会出现智力低下、特殊面容等情况,对于孩子来说也是一种不小的打击。

移植通常指胚胎移植,胚胎移植失败后胚胎一般会被身体吸收或是排出体外,当然移植失败后一定要去医院复查,密切观察胚胎组织是否完全排出体外。
1、身体吸收:胚胎通常是一种细胞团,如果胚胎移植失败,胚胎没有成功发育,细胞组织可能会逐渐凋亡,并被身体代谢吸收掉;
2、排出体外:如果将受精卵移植到子宫内后,因不注意卧床休息、活动量较大或盲目进行性生活,导致受精卵无法着床,出现阴道异常出血,此时胚胎可能会随血液排出体外。胚胎移植失败后,体内的激素水平会发生变化,子宫内膜会逐渐脱落形成月经。如果此时胚胎没有完全被身体吸收,也可能会随着子宫内膜的脱落排出体外。
总之,三代试管胚胎缺陷强行移植会出现很多问题,尤其是对女性的身体造成影响、胚胎移植后先兆流产、胚胎停育等等,所以为了避免这些危险,一般都会放弃。


相关推荐